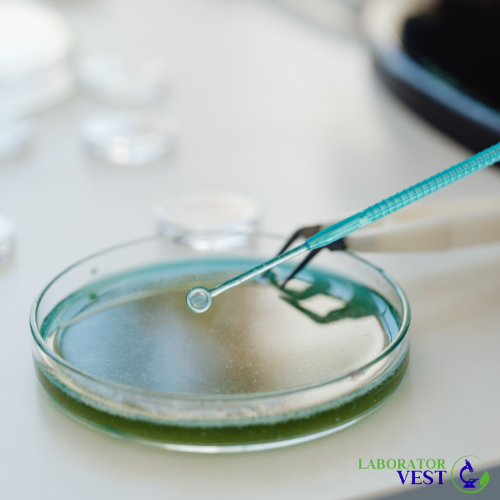

Firmele de la care importam produsele sunt firme de marca, cu renume in lumea de specialitate, certificate in sistem ISO 9001: Hirschmann Laborgeraete, Whatman, Greiner, Kern, Deutsch & Neumann, Bochem, Vitrum, Buerkle, Vitlab, Winzer.
Conditiile comerciale sunt flexibile, produsele se expediaza la sediul dvs.
Pentru informatii despre preturi pentru anumite produse, ne puteti contacta telefonic sau prin e-mail si veti primi un raspuns in cel mult 48 de ore.
In functie de bugetul de care dispuneti, vom defini oferta cea mai buna pentru a acoperi necesarul dvs.
Pe langa produsele de calitate garantata pe care vi le oferim, puteti beneficia de experienta noastra in domenii vaste si diverse ale muncii de laborator. Pe baza ei va putem indruma in alegerea aparaturii, ustensilelor si sticlariei necesare pentru activitatea dvs., mergand pana la proiectarea unui punct de lucru sau laborator.

Ce sunt NutriDisk-urile si care este utilitatea lor? Care sunt caracteristicile sticlei DURAN? Care este cea mai buna alternativa la tesaturile din azbest pentru stingerea incendiilor?
In aceasta pagina veti gasi raspunsuri la intrebarile anterioare si multe alte informatii utile din acest domeniu.
Laborator Vest SRL
sat Urseni, comuna Mosnita Noua,
str. Pietroasa, nr. 5,
jud. Timis, Romania
web design by DOW MEDIA